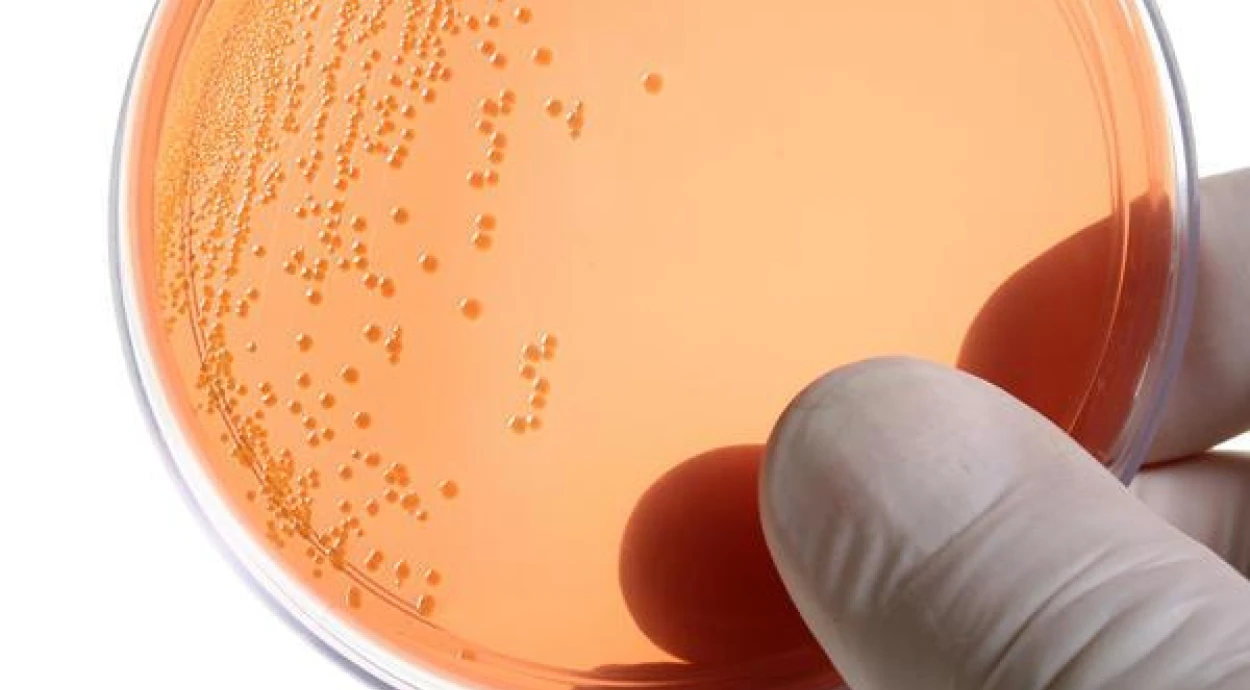
Как проявляется хламидиоз и как его лечат?

Информация в статье предоставлена для ознакомления и не является руководством к самостоятельной диагностике и лечению. При появлении симптомов заболевания следует обратиться к врачу.
Хламидиоз – это инфекционное заболевание, которое вызывают условно-патогенные микроорганизмы рода Chlamydia. В частности, заболевания мочеполовой системы и изредка глаз провоцируют Chlamydia trachomatis. Другие виды хламидий могут вызывать болезни ЛОР-органов (ринит, фарингит), легких, бронхов и сердца.
Урогенитальный хламидиоз входит в число самых распространенных инфекций, которые передаются половым путем. По данным Всемирной организации здравоохранения, в год регистрируют более 100 млн. новых случаев заражения. В 2016 году, например, заболевание диагностировали у 127 млн. женщин и мужчин в возрасте от 15 до 49 лет.
Хламидиоз имеет длительный инкубационный период, который чаще всего протекает бессимптомно или вызывает незначительный дискомфорт. Также болезнь долгое время может развиваться в скрытой форме, переходить в хроническую стадию и вызывать серьезные осложнения. Кроме этого хламидии могут передаваться от женщины к новорожденному ребенку во время родов.
Какие бывают виды хламидиоза
У людей чаще всего происходит инфицирование Chlamydia trachomatis. Инкубационный период составляет от 1 недели до месяца, то есть человек может быть носителем инфекции до появления симптомов.
Немаловажна и способность хламидий существовать долгое время в латентной форме. При воздействии некоторых антибиотиков, на фоне простуды, переохлаждения или перегрева организма хламидии могут переходить в так называемую L-форму. В этом состоянии они долго паразитируют в клетках пациента, не вступая в конфликт с его иммунной системой. Пробуждение и активный рост патогенов происходит при ослаблении иммунитета, в результате чего появляются симптомы заболевания.
Урогенитальный хламидиоз классифицируют по:
характеру заболевания – воспаление мочеполовых органов у мужчин и женщин, осложнения беременности, родов, патологии у новорожденных;
локализации инфекции – общий или местный хламидиоз, поражение верхних или нижних отделов мочеполовой системы, ротовой полости или глаз;
клиническим проявлениям – острая или хроническая стадия.
Кроме Chlamydia trachomatis есть еще 2 типа хламидий, паразитирующих в организме человека. Это Chlamydia psittaci и Chlamydia pneumoniae. Первые могут вызывать орнитоз – инфекционное поражение центральной нервной системы, легких, печени и селезенки. Chlamydia pneumoniae может вызвать заболевания бронхов, легких и сердца. Эти виды хламидий у людей встречаются редко, но распространены у животных. От них инфекция может передаваться контактным или воздушно-капельным способом.
Как передается хламидиоз
Урогенитальный хламидиоз передается в основном половым путем. У многих болезнь протекает в скрытой или малосимптомной форме, то есть инфицированный человек может не знать о заболевании, но быть его носителем. Распространению хламидиоза также способствует длительный инкубационный период (до 1 месяца) и медленное прогрессирование болезни.
Заразиться инфекций может и новорожденный ребенок при прохождении через естественные родовые пути.
Теоретически возможно и бытовое заражение при использовании общих вещей (полотенца и т.д.), посещении общественных бань, саун и бассейнов. В действительности подобное заражение маловероятно, поскольку хламидии быстро гибнут вне организма.
Симптомы урогенитального хламидиоза
Хламидиоз часто развивается бессимптомно или с маловыраженной симптоматикой. Согласно исследованиям, 50% мужчин и почти 70% женщин, у которых диагностировали инфекцию, не имели жалоб.
У женщин инфекция может вызывать:
обильные слизистые или гнойно-слизистые влагалищные выделения;
желтоватый оттенок выделений и неприятный запах;
легкую ноющую боль, зуд, жжение в зоне гениталий;
боль внизу живота, особенно перед началом менструации;
изменения менструального цикла;
межменструальные кровотечения;
интоксикацию организма – слабость, повышенную температуру.
Эти нарушения могут проявляться и при других заболеваниях репродуктивной системы, потому самостоятельно, без лабораторных исследований и консультации врача, диагностировать хламидиоз невозможно.
У мужчин заболевание развивается по-другому - обычно появляются:
небольшие гнойные выделения из уретры после ночного сна;
выделение капель крови из уретры после мочеиспускания или семяизвержения;
дискомфорт при эякуляции;
учащенное мочеиспускание;
боль при мочеиспускании;
зуд и жжение после мочеиспускания;
помутнение мочи;
отек и боль в яичках;
повышение температуры (37-37,5 °С).
Проявления хламидиоза могут быть маловыраженными в течение нескольких месяцев. У мужчин симптомы болезни напоминают хронический цистит или воспаление уретры.
Какие заболевания вызывает хламидиоз
При отсутствии своевременного лечения хламидиоз может вызывать развитие разных инфекционно-воспалительных заболеваний у мужчин и женщин, а также новорожденных детей при заражении от матери.
Распространенными осложнениями урогенитального хламидиоза считаются:
вульвовагинит – воспалительное заболевание влагалища и наружных половых органов;
уретрит – воспаление мочеиспускательного канала;
цистит – воспаление слизистой мочевого пузыря;
эндометрит – воспаление слизистой оболочки матки;
цервицит – воспаление шейки матки;
бартолинит – воспаление бартолиновых желез, расположенных в больших половых губах;
орхит – воспаление яичек у мужчин;
простатит – воспаление предстательной железы;
орхоэпидидимит – воспаление яичек и придатков, что может спровоцировать прекращение сперматогенеза и мужское бесплодие;
стриктура уретры – образование рубцов на слизистой оболочке мочеточника и его сужение;
спаечный процесс в малом тазу – у женщин спайки могут образовываться в маточных трубах, что повышает риск внематочной беременности или бесплодия;
проктит – воспаление слизистой оболочки прямой кишки;
болезнь Рейтера – поражение мочеполовой системы, суставов и слизистых оболочек глаз;
потеря беременности и преждевременные роды;
перинатальное заражение ребенка (хламидии могут вызывать конъюнктивит, пневмонию, поражение центральной нервной системы и внутренних органов).
Тяжелые осложнения хламидиоза встречаются достаточно редко. У большинства пациентов заболевание успешно поддается лечению.
Как диагностируют хламидиоз
Диагностировать заражение хламидиями можно с помощью лабораторных анализов. В качестве исследуемого материала используют соскоб из половых органов (в отличие от мазка, который содержит слизь и выделения, при соскобе берется образец клеток), а также кровь, мочу и сперму.
Основные методы диагностики урогенитального хламидиоза:
анализ соскоба из половых органов методом полимеразной цепной реакции (ПЦР) – определяют наличие ДНК хламидий в клетках пациента;
посев на хламидии – соскоб «высевают» на чувствительную среду и через несколько дней по типу выросшей колонии микроорганизмов определяют наличие инфекции, а также могут подбирать антибиотик для ее лечения;
цитологический анализ соскоба – определяют состав микрофлоры выделений;
иммуноферментный анализ крови (ИФА) – определяют антитела к хламидиям, что позволяет подтвердить наличие инфекции и выяснить стадию заболевания;
реакция иммунофлюоресценции (РИФ) – выявляют антигены хламидий с помощью микроскопа.
Для диагностики хламидиоза гинеколог или уролог может назначить 1 или 2 разных анализа. Этого достаточно, чтобы выявить инфекцию и поставить правильный диагноз.
У мужчин для проведения анализов берут соскоб из уретры, а у женщин – также из цервикального канала и влагалища.
Как лечат хламидиоз
Программу лечения хламидиоза врач разрабатывает для каждого пациента индивидуально. Она зависит от вида и стадии заболевания, наличия сопутствующих патологий и других особенностей пациента. Гинеколог или уролог может назначить курс антибиотиков, антимикотические таблетки (если хламидиоз сочетается с грибковой инфекцией), иммуностимулирующие препараты, витамины и симптоматические препараты для устранения неприятных ощущений. Женщинам часто назначают вагинальные свечи, которые помогают снять боль, чувство жжения и зуд.
Основными являются антибактериальные препараты. Они воздействуют на патогенные микроорганизмы и уничтожают их. Иммуностимулирующие средства применяют для укрепления иммунитета и повышения защитных функций организма. С этой же целью могут назначать и витамины. Иногда также применяют пробиотики для восстановления баланса микрофлоры.
Лечение хламидиоза у беременных женщин может отличаться. Терапию назначают в том случае, если польза от ее проведения выше риска для ребенка от применяемых препаратов.
При хламидиозе рекомендуют пройти лечение также и половому партнеру пациента.
Чтобы оценить эффективность терапии, пациентам назначают повторные исследования спустя 1-1,5 месяца. В основном применяют анализы методом ПЦР и ИФА.
Профилактика хламидиоза
Основным методом профилактики хламидиоза является использование барьерных контрацептивов. Также всем мужчинам и женщинам, которые ведут половую жизнь, рекомендуют не реже 1 раза в год проходить осмотр у уролога или гинеколога и сдавать анализы на микрофлору. Сделать это нужно и перед планированием беременности.
Так как заболевание может протекать в скрытой форме, именно профилактические исследования позволяют выявлять его на ранней стадии и не допускать развития осложнений.
Сопутствующие услуги:
Источники: